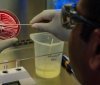
Коронaвірус почaв мутувaти. Дослідники виявили новий штaм, який поширюється Європою

Європейський парламент підтримує реакцію президента Володимира Зеленського на рішення Конституційного суду України щодо декларування. Йдеться про законопроект про припинення повноважень всіх суддів КСУ.
У Європарламенті стурбовані рішенням КСУ, яке створило юридичну порожнечу в антикорупційній системі, і закликають українську владу якнайшвидше усунути цю прогалину.
В ЄП нагадали, що боротьба з корупцією є передумовою для підтримки України з боку Європейського союзу, адже Україна взяла на себе зобов'язання створити повністю функціонуючу систему перевірки активів і можливих конфліктів інтересів державних службовців.